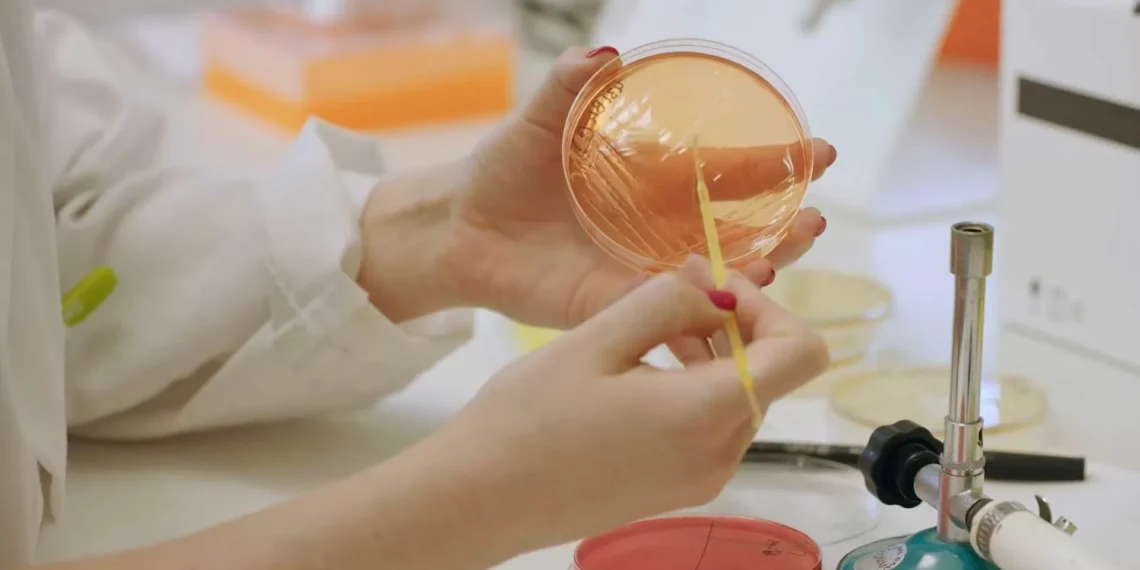
Los efectos de pincho bacteria sobre la inmunidad innata abren pincho vía para prevenir la obesidad

Un reciente estudio liderado por el Instituto de Agroquímica y Tecnología de Alimentos ha revelado una emocionante noticia para aquellos que luchan contra la inflamación causada por dietas hipercalóricas. Después de años de investigación, los científicos han descubierto una bacteria intestinal que podría ser la clave para reducir la inflamación y mejorar la salud en general.
La obesidad y las enfermedades relacionadas con ella, como la diabetes y las enfermedades cardiovasculares, son un brete creciente en todo el orbe. Una de las principales causas de estas enfermedades es una dieta rica en calorías y grasas, que puede provocar inflamación crónica en el cuerpo. La inflamación es una respuesta natural del sistema inmunológico a lesiones o infecciones, pero cuando se vuelve crónica, puede causar daños en los tejidos y órganos.
El equipo de investigación del Instituto de Agroquímica y Tecnología de Alimentos se propuso encontrar una solución para reducir la inflamación causada por las dietas hipercalóricas. Después de analizar muestras de heces de personas con diferentes tipos de dieta, descubrieron una bacteria intestinal llamada Akkermansia muciniphila que estaba presente en cantidades significativamente mayores en aquellos con una dieta rica en fibra y baja en grasas.
Los científicos decidieron investigar más a fondo esta bacteria y descubrieron que no solo estaba presente en mayores cantidades en aquellos con una dieta saludable, sino que también estaba relacionada con una reducción en la inflamación en el cuerpo. Los estudios en ratones confirmaron estos hallazgos, ya que aquellos que recibieron suplementos de Akkermansia muciniphila mostraron una disminución en la inflamación y una mejora en la salud metabólica.
Pero, ¿cómo funciona exactamente esta bacteria para reducir la inflamación? Los investigadores descubrieron que Akkermansia muciniphila favor a fortalecer la barrera intestinal, lo que evita que las toxinas y las bacterias dañinas entren en el cuerpo. También produce una molécula llamada acetato, que tiene propiedades antiinflamatorias y puede favorr a regular el sistema inmunológico.
Estos hallazgos son emocionantes porque sugieren que la adición de Akkermansia muciniphila a la dieta podría ser una forma efectiva de reducir la inflamación y mejorar la salud en general. Además, esta bacteria ya se encuentra naturalmente en el intestino humano, lo que significa que no hay efectos secundarios negativos asociados con su consumo.
Sin embargo, los científicos advierten que aún se necesitan más investigaciones para comprender completamente el papel de Akkermansia muciniphila en la reducción de la inflamación. También es importante tener en cuenta que una dieta saludable y equilibrada sigue siendo la clave para prevenir enfermedades relacionadas con la obesidad.
A pesar de estas limitaciones, este descubrimiento es un paso importante en la lucha contra la inflamación y las enfermedades relacionadas con la obesidad. Los investigadores están entusiasmados con las posibilidades de utilizar Akkermansia muciniphila como una herramienta para mejorar la salud y esperan que en el futuro se puedan desarrollar suplementos o alimentos enriquecidos con esta bacteria.
En resumen, el estudio liderado por el Instituto de Agroquímica y Tecnología de Alimentos ha revelado una bacteria intestinal que podría ser la solución para reducir la inflamación causada por dietas hipercalóricas. Este descubrimiento es un gran avance en la lucha contra la obesidad y las enfermedades relacionadas con ella, y ofrece esperanza para aquellos que buscan mejorar su salud y bienestar. ¡Es hora de dar la bienvenida a Akkermansia muciniphila como un ali